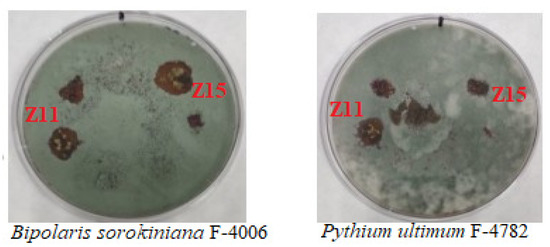

Abstract
Plant growth-promoting (PGPR) bacteria are beneficial soil bacteria that enhance plant growth against biotic and abiotic stress. Numerous studies have been carried out over the past three decades on the isolation and characterization of rhizospheric bacteria. However, no studies have been conducted on the bacteria present in the rhizosphere of the wild legume plant Chamacytisus ruthenicus when growing in chalky soil. The purpose of this study was to evaluate the abundance of culturable bacteria, assess the morphology of the bacterial cells, profile the chalky soil bacterial community, and characterize its ability to stimulate plant growth. Three soil samples were collected in January at a temperature of 2–4 °C. The first sample was taken from the topsoil, the second sample from the soil 15 cm beneath the surface, and the third sample from the rhizosphere. The results of the study revealed that the abundances of bacteria in the first, second, and third soil samples were 4.25 × 108 cfu/g, 3.58 × 108 cfu/g, and 10.1 × 107 cfu/g, respectively. Furthermore, a total of 23 rhizospheric bacteria were isolated based on differences in their morphological characteristics. The 16S rRNA soil profiling result showed that bacteria belonging to Proteobacteria, Actinobacteria, Gemmatimonadetes, Acidobacteria, and Bacteroidetes were the most dominant groups in the community. Six bacterial isolates (Z10, Z11, Z12, Z15, Z26, and Z44) were chosen to examine the inhibition effects on phytopathogenic microbes and their ability to promote plant growth. The bacterial isolates Z11 and Z15 showed good inhibition against all tested phytopathogenic fungi, while bacterial isolates Z10, Z12, Z15, Z26, and Z44 showed stimulatory effects on the length and fresh weight of the shoots and roots of wheat, maize, and oat seeds. In conclusion, the present study is the first report of chalky soil-associated bacteria found in the rhizosphere of the wild legume plant in the Belgorod region of Russia.
1. Introduction
Agro-chemical usage in contemporary agriculture has raised public concern because of its negative effects on the environment and animal health [1]. According to several studies [2,3], plant growth-promoting rhizobacteria (PGPR) have often been utilized as a potential substitute for agro-chemicals. PGPR is a naturally occurring soil bacterium that lives in a plant rhizosphere and promotes plant growth, either directly or indirectly [4,5]. Nevertheless, the mode and mechanism of PGPR activity differ depending on the host plant species, soil type, and nutritional status of the soil [6]. The majority of PGPR isolates cause a notable increase in plant height, root length, and dry matter production in the plant’s shoots and roots. On the other hand, some PGPR affect plant health by inhibiting the growth of phytopathogens [6,7]. Since the last few decades, several PGPR species from the genera Azospirillum, Pseudomonas, Klebsiella, Azotobacter, Enterobacter, Alcaligenes, Bacillus, Burkholderia, Serratia, Herbaspirillum, Acinetobacter, Aeromonas, Agrobacterium, Bradyrhizobium, and Xanthomonas have been reported as effective plant growth promoters [4,6,8,9]. Today, researchers are still looking for potential PGPR in the rhizospheres of different plant species. However, no research has been conducted on chalky soil bacteria present in the rhizosphere of Chamaecytisus ruthenicus. Therefore, the aim of the present study was to evaluate the abundance of culturable bacteria, assess the morphology of the bacterial cells, profile the bacterial community in chalky soil, and characterize its ability to stimulate plant growth.
2. Methods
2.1. Soil Sample Collection
Soil samples were collected from non-agricultural soil of the Belgorod region of the Russian Federation. The location of the site was at 36.484050° N latitude and 50.579872° E longitude. Three chalky soil samples were randomly collected in January 2023 at a temperature range of 2–4 °C. The first sample was taken from the top layer of the soil, the second from 15 cm beneath the surface, and the third from the rhizosphere. Each soil sample was placed in a sterile polythene bag and brought to the laboratory for immediate analysis, and the remainder was stored at 4 °C for further study.
2.2. Bacterial Abundance and Isolation
The colony-forming units (CFU) of soil bacteria were estimated using the serial dilution technique, as described in [10], with a few modifications. Five grams from each soil sample were suspended in 50 mL of sterilized water. After being serially diluted, 100 μL from each (103–105) dilution was transferred onto plates containing reduced concentrations of Luria-Bertani (LB) growth medium (composition: yeast extract 1 g/L, peptone 2 g/L, sodium chloride 5 g/L, and agar 20 g/L). Then, the plates were incubated at 29 °C for 48 h. The colonies that appeared on the plates after 48 h of incubation were counted. After purification, the bacterial colonies were isolated on the basis of their color, shape, size, and pigment. Then, the purified colonies were reserved in the refrigerator for further study.
2.3. Microscopy Examination of Bacterial Isolates
Light microscopy of samples in phase contrast mode was carried out using a Nikon Eclipse Ci microscope (Nikon, Tokyo, Japan) equipped with a ProgRes SpeedXT camera (Jenoptic, Jena, Germany).
2.4. Soil Profile by 16S rRNA Gene Amplicon Sequencing
Sequence analysis was performed using the QIIME2 v.2022.2 software [11] and the MicrobiomeAnalyst 2.0 web service [12]. Sequence quality control was carried out using the deblur plugin [13] in positive mode. Then, SortMeRNA was used, where all raw reads were compared to the GreenGenes reference database [14]. The remaining sequences were assigned a taxonomy using a pretrained classifier (Naive Bayes classifiers) that was assembled from the complete 16S rRNA gene sequence using the GreenGenes reference database [14]. To assess biodiversity, alpha (Shannon, Pielow index, observed OTUs) and beta diversity indices (uniFrac “unweighted” and “weighted” methods) were calculated. The results are presented using PCoA multivariate statistical methods (principal component analysis).
2.5. Bacterial Inhibition against Phytopathogenic Microbes
Bacterial inhibition tests were examined using six bacterial isolates (Z10, Z11, Z12, Z15, Z26, and Z44) against three phytopathogenic bacteria (Erwinia herbicola ATCC 27155, Pectobacterium carotovorum B15, and Micrococcus roseus B1236) and five phytopathogenic fungi (Fusarium avenaceum F-132, Rhizoctonia solani F-895, Alternaria brassicicola F-1864, Bipolaris sorokiniana F-4006, and Pythium ultimum F-4782). The phytopathogenic microbes were obtained from the Microbiology Regional Center, Belgorod State University, Belgorod Region, Russia. The bacterial isolates and the phytopathogenic microbes were cultured and incubated at 29 °C for five and three days, respectively. To examine the inhibition effect, 100 μL of each phytopathogenic bacterium was added to plates containing LB and distributed with sterile glass beads. Then, 5 μL of each bacterial isolate was distributed evenly throughout the plates. Similarly, a small piece of a fungal body was put in the middle of a plate containing Sabouraud dextrose agar, and 5 μL of bacterial isolate was sprinkled around the fungal body. All plates were incubated at 29 °C for 48 h. The occurrence of inhibition zones around the bacterial strains indicated the inhibition effect.
2.6. Bacterial Growth Stimulation Effect on Seed Germination
In a well-controlled experiment, seed germination was performed to evaluate the effects of bacterial stimulation on the development of four seeds (wheat, maize, oats, and lentils). In 10 mL of LB liquid medium, six bacterial strands were cultured and incubated at 29 °C for 72 h. On a total of 28 plates, 25 seeds from each variety were distributed. Thereafter, except for the control group, 15 mL of bacterial solution that had been diluted to an OD600 of 0.1 was applied to each plate. The control group, however, received merely water as an addition. For a week, 15 mL of water was added to the plates each day. The growth stimulation experiment was performed in triplicate. The lengths and fresh weights of the shoots and roots of the seedlings were measured and compared after the seeds had germinated. The data were statistically evaluated using a t-test at p = 5%.
3. Results
3.1. Abundance and Isolation of Chalky Soil Bacteria
The abundance of bacteria isolated from the three soil samples was computed. The highest bacterial concentration (4.25 × 108 cfu/g) was recorded in the initial soil sample, while the bacterial concentration in the second soil sample was 3.58 × 108 cfu/g. Nevertheless, the bacterial concentration in the third soil sample was 10.1 × 107 cfu/g, which is relatively low. Following repeated purification of the bacterial colonies, a total of 23 chalky soil bacteria were isolated based on morphological differences.
3.2. Morphology of the Isolated Strains
Bacteria with a wide range of morphologies are found in chalky soil. In Figure 1, the morphology of bacterial cells is shown. The representative bacterial cells are shaped like either rods, spheres, or filaments. Also, a few of the bacterial cells contained spores.

Figure 1.
The morphological diversity of chalky soil bacterial cells: (a) branching aerial mycelium of actinomycete—producer of bright orange pigment; (b) streptococci; (c) diplobacilli with spores; (d) thin, long, rod-shaped cells forming rosettes; (e) unevenly dividing rod-shaped cells. Scale bar is 10 μm.
3.3. Profile of Soil Bacteria Community
The results of the soil profile presented in Figure 2 revealed that the chalky soil bacterial community comprised 19 phyla of bacteria. Based on the comparison of the average relative abundance, the bacterial community was clustered into three groups (major, medium, and minor phyla). The group Proteobacteria was the most dominant and cosmopolitan among the listed chalky soil bacterial community. Furthermore, the genus Arenimonas (belonging to Proteobacteria) was the most numerous genus in all soil samples. However, Flavobacterium (which belongs to Bacteroidetes) was the most dominant genus in the rhizosphere. The results of the bacterial alpha diversity analysis showed a significant abundance of species with an uneven distribution of taxa in the samples. The results of the PCoA analysis of the community structures of bacteria showed that there was a difference between samples, but according to the results of the PERMANOVA analyses, there were no significant differences in β diversity among the groups.

Figure 2.
The average relative abundance of the phyla of the chalky soil bacterial community in soil samples 1 and 2 (a) and in the rhizosphere (b).
3.4. Bacterial Inhibition against Phytopathogenic Microbes
The results of the bacterial inhibition test presented in Table 1 revealed that most of the tested bacterial isolates showed inhibition effects against Micrococcus roseus B1236. Nevertheless, no bacterial isolates exhibited inhibition effects against either Erwinia herbicola ATCC 27155 or Pectobacterium carotovora B15. In contrast, bacterial isolates Z11 and Z15 showed inhibitory effects against all tested phytopathogenic fungi. The inhibition zone presented in Figure 3 indicates that these two bacterial strains exhibited a potent inhibitory impact on Pythium ultimum F-4782 and Bipolaris sorokiniana F-4006.

Table 1.
Antagonistic test against phytopathogenic microbes.
Figure 3.
Inhibition zone shown by bacterial isolates against phytopathogenic fungi.
3.5. Bacterial Growth Stimulation Effect on Germinated Seeds
The growth stimulation effect of bacterial isolates on the lengths and fresh weights of the shoots and roots of the germinated seeds is presented in Figure 4. In Figure 4a, it is shown that the bacterial isolate Z10 caused a significant increase in the shoot length of wheat. Whereas bacterial isolates Z11, Z12, Z15, Z26, and Z44 led to significantly increased shoot length in oats. Moreover, bacterial isolates Z10 and Z11 induced a significant increase in the shoot length of lentils (p = 0.05). On the other hand, the stimulation effect on root length shown in Figure 4b revealed that no bacterial isolates showed significant changes in the root lengths of wheat, maize, or lentils. However, bacterial isolate Z11 significantly decreased the root length of oats (p = 0.05). In the case of stimulation effects on the fresh weights of shoots and roots represented in Figure 4c,d, bacterial isolates Z10 and Z12 led to significant increases in the fresh weights of the shoots and roots of lentils, respectively. Furthermore, bacterial isolates Z15 and Z26 also caused significant increases in the fresh weights of the shoots and roots of maize, respectively (p = 0.05).

Figure 4.
The growth stimulation effect on the shoot length (a), root length (b), shoot fresh weight (c), and root fresh weight (d) by chalky soil bacterial isolates on the germinated seeds of wheat, maize, oats, and lentils.
4. Discussion
The usage of PGPR as a biofertilizer and/or biocontrol agent is a crucial tactic for environmentally friendly and sustainable farming methods. The most often documented PGPR bacteria that encourage plant development and inhibit phytopathogenic microorganisms mostly come from the genera Bacillus and Pseudomonas [5]. In the present investigation, a total of 23 different kinds of chalky soil bacteria were isolated from the rhizosphere of wild legume plants. As compared to other soil types, the average chalky soil bacterial abundance in the current study was 2.95 × 108 cfu/g, which is low. In sandy, clay, and loamy soil, for instance, the bacterial populations are 1.9 × 109 cfu/g, 1.8 × 1010 cfu/g, and 2.3 × 1010 cfu/g, respectively [15]. Based on the results of the soil profile using 16S rRNA gene sequencing, around 19 different chalky soil bacterial groups were described. The predominant bacterial phyla in all soil samples were Proteobacteria, Actinobacteria, Gemmatimonadetes, Acidobacteria, and Bacteroidetes. Many crop plants were damaged by phytopathogenic fungi such Alternaria sp., Rhizoctonia solani, Pythium ultimum, and Fusarium solani [16]. In the present study, bacterial isolates Z10, Z11, Z12, Z15, Z26, and Z44 showed good inhibition effects on the tested phytopathogenic microbes. In particular, bacterial isolates Z11 and Z15 showed strong inhibition effects against Pythium ultimum and Bipolaris sorokiniana. Moreover, bacterial isolates Z10, Z12, Z15, Z26, and Z44 had better growth-stimulating effects on the lengths and fresh weights of shoots and roots of the germinated seeds of wheat, maize, oats, and lentils.
5. Conclusions
The current study was conducted to assess the isolation and characterization of soil bacteria found in the rhizosphere of Chamaecytisus ruthenicus growing in chalky soil. In the present study, the average abundance of chalky soil bacteria varied from 10.1 × 107 cfu/g in the rhizosphere to 4.25 × 108 cfu/g in chalky soil. On the other hand, the chalky soil contained bacteria with a wide range of morphologies. From the listed bacterial community, Proteobacteria was the most dominant and cosmopolitan group of bacteria. Furthermore, the chalky soil bacterial isolates Z10, Z11, Z12, Z15, Z26, and Z44 showed inhibition activity against the phytopathogenic bacteria Micrococcus roseus B1236 and all the tested phytopathogenic fungi. In addition, bacterial isolates Z10, Z12, Z15, Z26, and Z44 showed plant growth-stimulating effects on the germinated seeds of wheat, maize, and oats. In the future, further investigations will be carried out on these potent chalky soil bacterial isolates. Finally, the present study is the first report of chalky soil-associated bacteria found in the rhizosphere of a wild legume plant in the Belgorod region of Russia.
Supplementary Materials
The following supporting information can be downloaded at: https://www.mdpi.com/article/10.3390/ECP2023-14709/s1.
Author Contributions
Conceptualization, I.P.S.; methodology, I.P.S.; software, Z.A.A.; validation, Y.K., Z.A.A. and Y.D.; formal analysis, Z.A.A.; investigation, Z.A.A., N.E.S., Y.K., Y.D.; resources, I.P.S.; data curation, Z.A.A. and Y.K.; writing—original draft preparation, Z.A.A., N.E.S. and Y.K.; writing—review and editing, Z.A.A., Y.D. and I.P.S.; visualization, N.E.S., Z.A.A.; supervision, I.P.S.; project administration, I.P.S.; funding acquisition, I.P.S. All authors have read and agreed to the published version of the manuscript.
Funding
This research received no external funding.
Institutional Review Board Statement
This article does not contain descriptions of studies with human participants or animals performed by any of the authors.
Informed Consent Statement
Not applicable.
Data Availability Statement
The data presented in this study are available on request from the corresponding author.
Conflicts of Interest
This authors declare no conflicts of interest in the financial or any other sphere.
References
- Singh, R.P.; Jha, P.D. The PGPR Stenotrophomonas maltophilia SBP-9 augments resistance against biotic and abiotic stress in wheat plants. Front. Microbiol. 2017, 8, 1945. [Google Scholar] [CrossRef] [PubMed]
- Palaniyandi, T.; Rahaman, M.; Wyson, J.; Viswanathan, S.; Basker, G.; Ranganathan, M. Isolation and Characterization of Halophilic Plant Growth Promoting Rhizobacteria from Marine Sediment, Water, and Coastal Sanddune Plant and It’s Screening for Plant Growth Regulators. Res. Sq. 2022. [Google Scholar] [CrossRef]
- Alaylar, B.; Gulluce, M.; Karadayi, M.; Koc, T.Y.; Karadayi, G. Rhizospheric PGPR Strains of Wheat, Barley and Trefoil Grown in Ağrı Province. Turk. J. Nat. Sci. 2021, 10, 182–190. [Google Scholar] [CrossRef]
- Bashir, U.; Ali, A.; Khtar, N.; Haider, M.S. Characterization of growth promoting rhizobacteria of leguminous plants. Pak. J. Phytopathol. 2016, 28, 57–60. [Google Scholar]
- Khan, A.; Agha, S.I.; Jamil, N.; Tabassum, B.; Ahmed, S.; Raheem, A.; Jahan, N.; Ali, N.; Azeem, S. Characterization and survival of broad-spectrum biocontrol agents against phytopathogenic fungi. Rev. Argent. Microbiol. 2022, 54, 233–242. [Google Scholar]
- Kalam, S.; Prasad, P.; Das, S.N.; Basu, A.; Sayyed, R.Z.; Reddy, M.S.; El Enshasy, H. Plant Growth Promoting Rhizobacteria (PGPR) as Green Bioinoculants: Recent Developments, Constraints, and Prospects. Sustainability 2021, 13, 1140. [Google Scholar]
- Saharan, B.S.; Nehra, V. Plant growth promoting Rhizobacteria: A critical review. Life Sci. Med. Res. 2011, 21, 30. [Google Scholar]
- Sezen, A.; Ozdal, M.; Algur, O.F. Isolation and Characterization of Plant Growth Promoting Rhizobacteria (PGPR) and Their Effects on Improving Growth of Wheat. J. Appl. Biol. Sci. 2016, 10, 41–46. [Google Scholar]
- Singh, T.B.; Sahai, V.; Ali, A.; Prasad, M.; Yadav, A.; Shrivastav, P.; Goyal, D.; Dantu, P.K. Screening and evaluation of PGPR strains having multiple PGP traits from hilly terrain. J. Biol. Biotechnol. 2020, 8, 38–44. [Google Scholar]
- Harsha, M.K.; Bhalerao, P.B.; Daunde, A.T.; Sakhare, S.S. Isolation and characterization of native bacterial antagonists from chickpea rhizosphere and their effect on disease suppression of fusarium wilt. Pharma Innov. J. 2023, 12, 2011–2018. [Google Scholar]
- Bollyen, E.; Rideout, J.R.; Dillon, M.R.; Bokulich, N.A.; Abnet, C.C.; Al-Ghalith, G.A.; Alexander, H.; Alm, E.J.; Arumugam, M.; Asnicar, F.; et al. Reproducible, interactive, scalable and extensible microbiome data science using QIIME 2. Nat. Biotechnol. 2019, 37, 852–857. [Google Scholar] [CrossRef] [PubMed]
- Dhariwal, A.; Chong, J.; Habib, S.; King, I.L.; Agellon, L.B.; Xia, J. MicrobiomeAnalyst: A web-based tool for comprehensive statistical, visual and meta-analysis of microbiome data. Nucleic Acids Res. 2017, 45, W180–W188. [Google Scholar] [CrossRef] [PubMed]
- Amir, A.D.; McDonald, D.; Navas-Molina, J.A.; Kopylova, E.; Morton, J.T.; Zech Xu, Z.; Kightley, E.P.; Thompson, L.R.; Hyde, E.R.; Gonzalez, A.; et al. Deblur rapidly resolves single-nucleotide community sequence patterns. mSystems 2017, 2, e00191-16. [Google Scholar] [CrossRef] [PubMed]
- Bokulich, N.A.; Kaehler, B.D.; Rideout, J.R.; Dillon, M.; Bolyen, E.; Knight, R.; Huttley, G.A. Optimizing taxonomic classification of markergene amplicon sequences with qiime 2’s q2-feature-classifier plugin. Microbiome 2018, 6, 90. [Google Scholar] [CrossRef] [PubMed]
- Nuhu, U.I.; Salisu, U. Bacteria isolate from different soil types contaminated with crude oil in Birnin Kebbi local government area, Kebbi state, Nigeria. Himal. J. Appl. Med. Sci. Res. 2022, 3, 39–47. [Google Scholar]
- Syed, A.; Shwaiman, H.A.; Shahid, M.; Elgorban, A.M.; Siddique, K.H. Beijerinckia fluminensis BFC-33, a novel multi-stress-tolerant soil bacterium: Deciphering the stress amelioration, phytopathogenic inhibition and growth promotion in Triticum aestivum (L.). Chemosphere 2022, 295, 133843. [Google Scholar]
Disclaimer/Publisher’s Note: The statements, opinions and data contained in all publications are solely those of the individual author(s) and contributor(s) and not of MDPI and/or the editor(s). MDPI and/or the editor(s) disclaim responsibility for any injury to people or property resulting from any ideas, methods, instructions or products referred to in the content. |
© 2023 by the authors. Licensee MDPI, Basel, Switzerland. This article is an open access article distributed under the terms and conditions of the Creative Commons Attribution (CC BY) license (https://creativecommons.org/licenses/by/4.0/).




